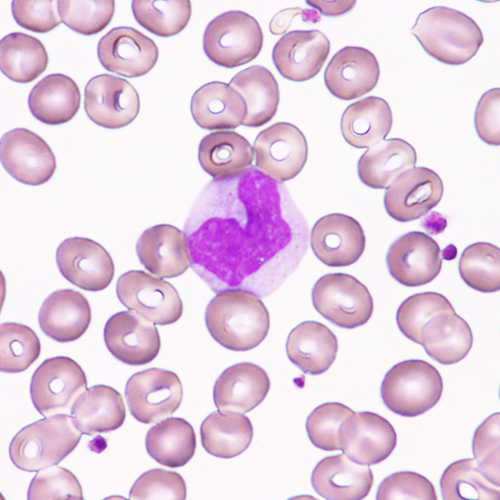

臨床検査室
検査について検体検査一覧に戻る
採血を受けられる方へ
当院では採血を安全に間違いなく行うために以下のことを確認させていただいております。
- ご本人さま確認
採血取り間違い防止のため、ご自身の氏名、お誕生日を確認させていただいております。
下記に該当する患者さんは採血スタッフにお申し出ください。
- 採血時にご気分の悪くなられる方
- 消毒液(アルコール)や手袋(ラテックス)にアレルギーをお持ちの方
- 血液透析中の方
- 乳房切除術を受けられた方
- その他採血に関してご希望・ご不安な点のある方
採血時の疑問やご不明な点は遠慮なくスタッフにお聞きください。
生化学免疫検査
- 肝機能・腎機能・糖代謝機能などの検査のほか、感染症や内分泌検査を行っています。
- 外来からの依頼は診察前検査として30分程度で報告しています。


糖代謝検査
血糖ならびにグリコヘモグロビンを測定する検査装置です。血糖は採血した時点の血糖の値を示し、グリコヘモグロビンは過去1~2か月の血糖の状態が分かります。


血液ガス分析装置
血液中の酸素や二酸化炭素の濃度、PHなどを調べる検査装置です。
血液検査
- 血液中の血球数を調べ貧血の程度や種類、また炎症の有無や出血を止める働きなどを調べています。顕微鏡による白血球分類や形態観察も行っています。
- 血液の凝固・線溶系に関する検査も行っています。
全自動血球分析装置
白血球数・赤血球数・血小板数の計測および白血球分類を行っています。
全自動凝固測定装置
凝固・線溶系の測定装置では、抗凝固薬療法(ワーファリン)などの指標となるPTや、血栓症を起こす病気の診断またはその重症度を調べるFDP、Dダイマーなどの項目を測定しています。
顕微鏡による血液像鏡検
医師による鏡検依頼があった場合や検査装置で分類できなかった白血球は顕微鏡により分類しています。

骨髄像鏡検


一般検査
尿の蛋白・潜血などを検査し、顕微鏡で尿中の白血球・赤血球などを調べています。また、インフルエンザや肺炎球菌などの各種迅速検査を行っています。
尿定性検査
試験紙により尿中の蛋白、潜血、PH、ケトン体などを調べます。
尿沈渣
尿を遠心分離し沈殿する赤血球・白血球・上皮細胞などを顕微鏡で調べる検査です。腎臓や尿路系の病気の診断に重要です。


迅速検査
インフルエンザ・アデノウィルス・肺炎球菌・レジオネラ等の迅速検査を実施し、早期治療に貢献しています。
輸血検査
- 輸血に伴う検査には、交差適合試験と不規則性抗体検査があります。
- 不規則性抗体検査はABO式血液型以外の血液型に対する抗体がないかを調べる検査です。
交差適合試験
交差適合試験は、重大な事故や副作用を防ぎ、安全に輸血を行うための重要な検査です。
輸血しようとする血液製剤と患者様の血液を試験管内で混ぜ、血液が固まったり、赤血球が壊れたりしないかを観察します。


全自動輸血検査装置を導入し、血液型および不規則抗体スクリーニングを検査しています。装置の導入により、検査の迅速化がはかれ、24時間同一レベルの精度で検査ができるようになりました。
輸血管理
当院は輸血総合管理システムを導入し、血液製剤の出入庫を含めた使用状況の管理、輸血関連検査に関する管理を行っています。
血液製剤の有効利用
赤血球製剤使用予定患者さまの血液データを臨床検査技師がチェックし、臨床検査室より主治医へ製剤使用の有無について確認の連絡を行っています。その結果、血液製剤の有効利用(廃棄率低下)に繋がりました。








